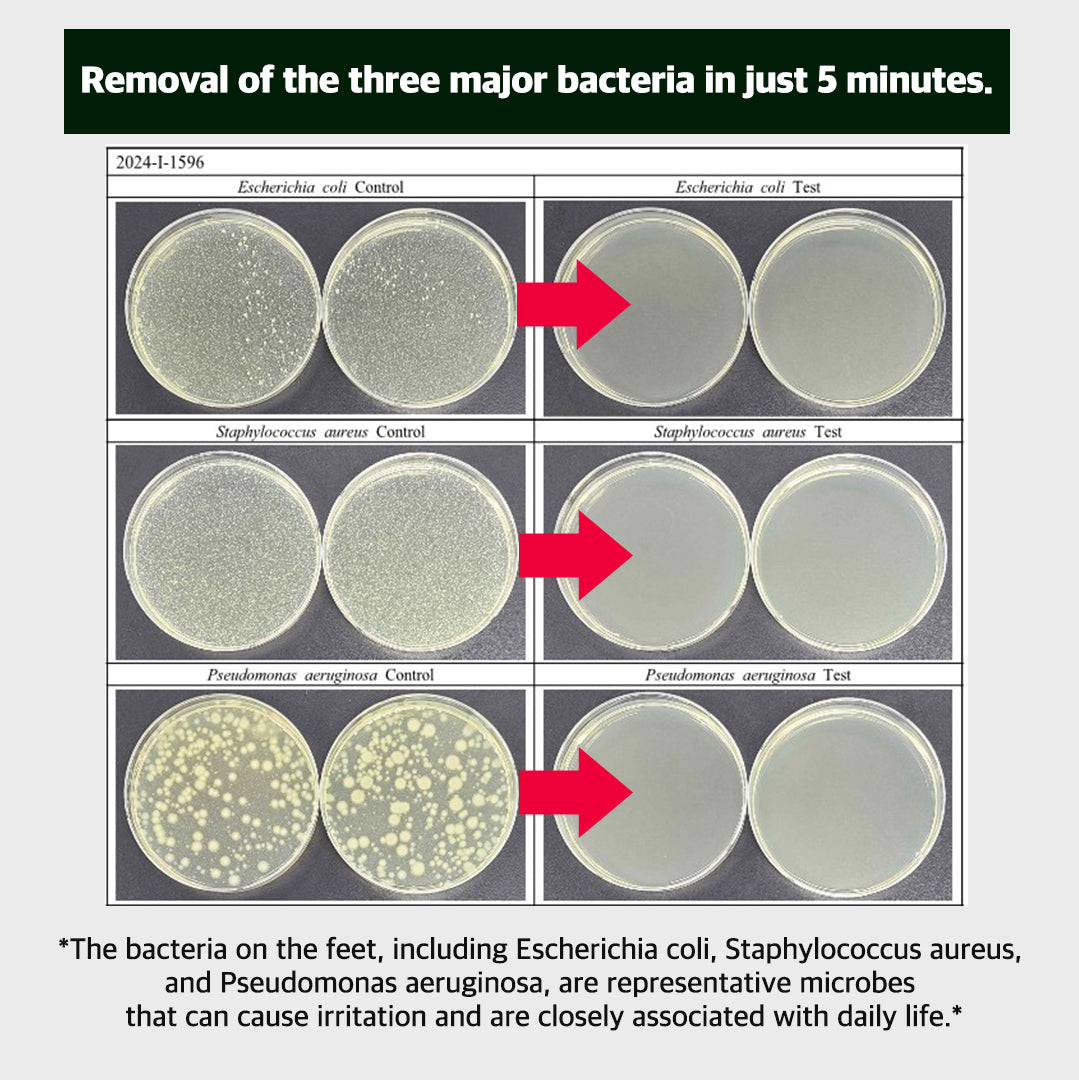
[USDA] TheAromaShop Organic Foot Care 100ml

USDA Organic Foot Care Mist (100ml)
Details
USDA Organic Foot Care Mist 3.38 fl oz
Refreshing daily care for odor, discomfort, and fatigued feet
-
USDA-certified organic formula for gentle, worry-free foot care
-
No-rinse mist for easy, anytime use to help reduce sweat and foot odor
-
Provides a cooling, refreshing feel to soothe tired feet
-
Supports clean, comfortable foot hygiene throughout the day

Free Shipping over $75
We ship quickly, with most orders leaving our warehouse within 2–3 business days.
Once your order ships, you’ll receive a confirmation email with tracking details so you can follow it every step of the way.
Officially Licensed
Support the biggest and most talented names in K-pop. Shop official-style, authenticated K-pop merch from your favorite artists—crafted with premium quality and attention to detail.
What To Expect?
This item arrives ready for display or collection. Packaging is selected to help preserve its condition during transit, so it reaches you in the best possible state for long-term keeping.
Popular Add-Ons